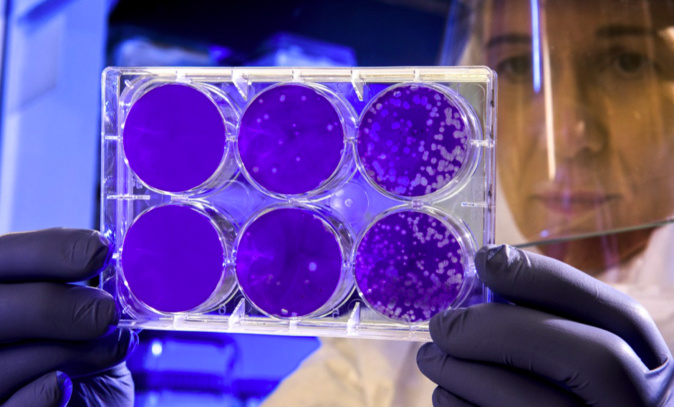
Coronavirus : troisième jour sans nouveaux cas en Corse Coronavirus : troisième jour sans nouveaux cas en Corse

Aucun nouveau cas, aucun nouveau décès n'a été enregistré en Corse au cours de ces 24 heures a fait savoir ce jeudi 28 mai, l'Agence régionale de la Santé .
Depuis le début de l'épidémie en Corse 73 patients ont perdu la vie à la suite de l'épidémie du Covid-19.
A noter encore que le nombre de patients hospitalisés est toujours stable depuis deux jours à l'hôpital d'Ajaccio (5 patients hospitalisés dont 3 en soins intensifs). Stationnaire est aussi la situation à Bastia où 2 personnes sont toujours en soins intensifs et 4 en hospitalisation conventionnelle.
L’ARS de Corse rappelle, encore, que pour réussir la levée progressive du confinement, il faut plus que jamais, appliquer scrupuleusement tous les gestes barrières, respecter la distanciation physique minimale d’un mètre et réduire le nombre de nos contacts.
Depuis le début de l'épidémie en Corse 73 patients ont perdu la vie à la suite de l'épidémie du Covid-19.
A noter encore que le nombre de patients hospitalisés est toujours stable depuis deux jours à l'hôpital d'Ajaccio (5 patients hospitalisés dont 3 en soins intensifs). Stationnaire est aussi la situation à Bastia où 2 personnes sont toujours en soins intensifs et 4 en hospitalisation conventionnelle.
L’ARS de Corse rappelle, encore, que pour réussir la levée progressive du confinement, il faut plus que jamais, appliquer scrupuleusement tous les gestes barrières, respecter la distanciation physique minimale d’un mètre et réduire le nombre de nos contacts.
-
Municipales. Julien Morganti : « Bastia a besoin d’un maire à temps plein »
-
Sporting club de Bastia-Boulogne : les premières images
-
Municipales. En Corse-du-Sud, plusieurs communes clefs sous haute tension avant le 1er tour
-
Municipales. Que proposent les candidats à la mairie d’Ajaccio pour lutter contre la précarité ?
-
Municipales. À Ota-Porto, Toussaint Maranelli veut « valoriser l’identité locale afin de donner un nouvel élan à la commune »

Envoyer à un ami
Version imprimable




